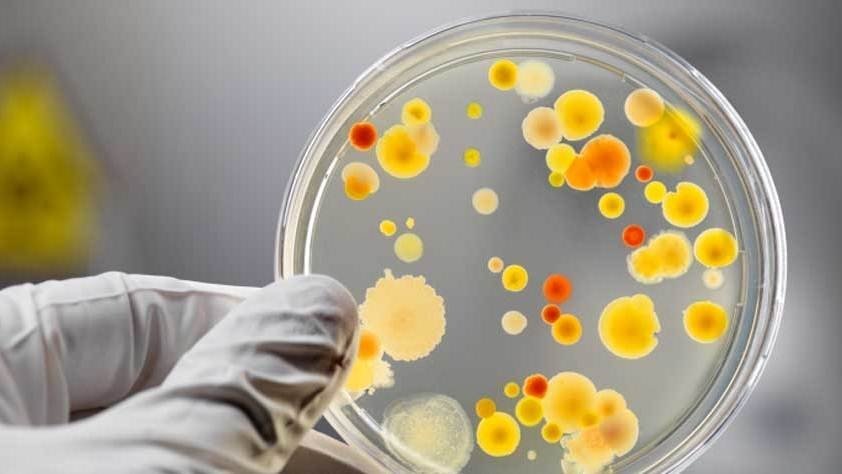

У заболевших кременчужан лабораторно подтвердился диагноз сальмонеллёз. Об этом «Телеграфу» сообщила инфекционист Лариса Коровина.
По её словам, результаты анализа пищевых продуктов, которые были взяты в домашнем очаге (яйца, курица и другие) ещё не готовы – их ожидают сегодня во второй половине дня либо завтра, 23 августа.
Как ранее сообщал «Телеграф», пятеро молодых кременчужан заболели сальмонеллёзом. Сами потерпевшие грешат на яйца, купленные в «АТБ». Магазин снял с реализации «подозрительную» партию продукции.
Специалисты устанавливают, что стало причиной заболевания.